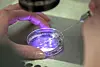

Etik
Förslag om utökad embryoforskning sågas: ”Människolivet instrumentaliseras”
Det bör vara tillåtet att forska på mänskliga embryon till 28 dagar efter befruktningen i stället för dagens gräns på 14. Det menar Statens medicinsk etiska råd (Smer) i en ny skrivelse. Per Landgren (KD) som är ledamot i Smer har reserverat sig.
”En potentiell nytta prioriteras framför det liv som det ska forskas på”, skriver han.
Smers ordförande försvarar dock förslaget.







